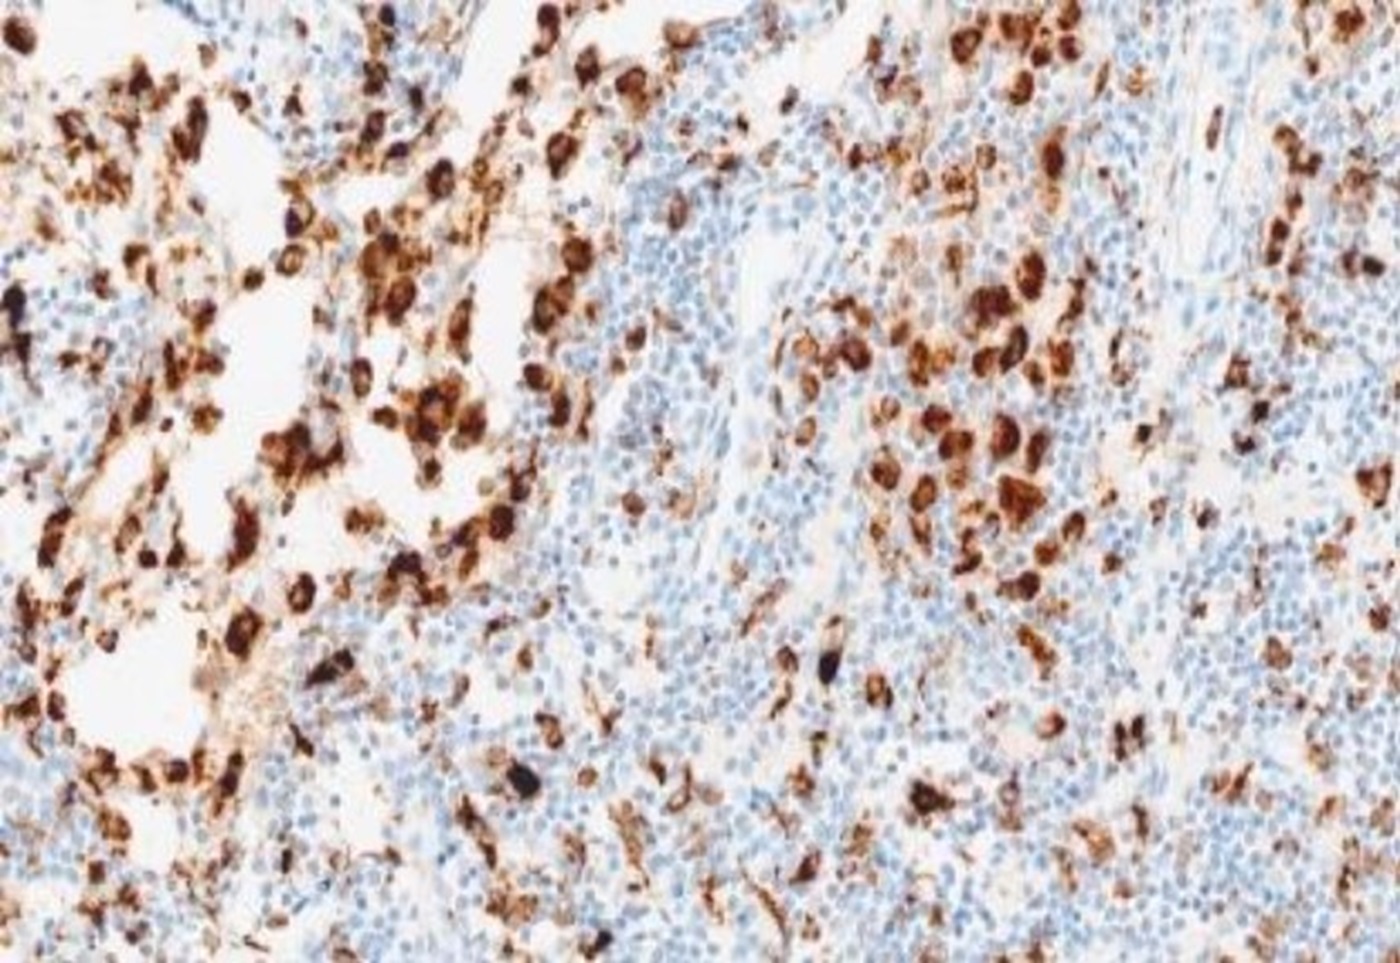
CD68 (SP251v18) Rabbit Monoclonal Antibody

A comprehensive portfolio of trusted testing solutions for blood cancers
Pushing the standards of diagnostic excellence higher for hematologic malignancies
Blood cancers or hematologic malignancies vary significantly in both prognosis and aggressiveness, demonstrating a need for tools that assist pathologists in making confident diagnoses and helping to inform clinical decisions.
At Roche, we are continuously improving diagnostics in this space guided by the top minds in medical science. We offer over 60 cornerstone and novel hematopathology ready-to-use reagents, including key immunohistochemistry (IHC) antibodies and in situ hybridization (ISH) probes, which aid in the diagnosis of hematologic malignancies.
By leveraging our comprehensive solutions to simplify and optimize clinical decisions, we provide confidence and a true commitment to helping you improve labs and lives through flexible, sustainable solutions and close collaboration with the global oncology community.
In 2023, Roche was rated among the top three most sustainable healthcare companies in the Dow Jones Sustainability Indices. This marked the 15th consecutive year in a leading position.1 Roche is continuously improving the hematopathology menu while pushing the boundaries of antibody optimization. By advancing recombinant technology that does not rely on native or animal resources, Roche ensures a reliable and sustainable supply for customers.2,3
The rising global burden of hematologic malignancies
Hematologic malignancies (lymphoma, leukemia, and multiple myeloma) are among the most common cancers globally, accounting for 1.3 million cases in 2019.4 Non-hodgkin’s lymphoma (NHL) is the most common lymphoma, accounting for 90% of lymphoma cases.5 Annually, there are over 550,000 NHL cases and 250,000 deaths, making it the 11th leading cause of cancer-related death.6
The 5-year overall survival rate for NHL patients is approximately 60%.7 However, relapse can be high. For example, in diffuse large B-cell lymphoma (DLBCL), the most common subtype of NHL, the relapse rate within the first two years of achieving remission after treatment is 50-60%.8
In the US, annual healthcare expenditure for each NHL patient is over $USD 21,000, significantly higher than other cancer groups.9
The challenge of a definitive lymphoma diagnosis
Lymphomas are heterogeneous at the clinical, morphological, and molecular levels, and have overlapping features – leading to the fragmentation of the diagnostic pathway.10
There is a diverse range of lymphoma subtypes and each falling under broader guidelines that recommend different testing and treatment modalities. For example, the National Comprehensive Cancer Network (NCCN) has several distinct guidelines for different hematologic malignancies, underlying the complexity of this group of diseases.11 On top of this, the Royal College of Pathologists recommends different sets of IHC markers and panels for different subtypes and diagnostic settings.12
According to the International Consensus Classification of Mature Lymphoid Neoplasms, there are multiple subcategories for mature B-cell neoplasm, classic Hodgkin lymphoma, and mature T-cell and NK-cell neoplasm.13 Furthermore, although DLBCL is the most common subtype of NHL, it often presents diagnostic challenges due to its diverse clinical presentation.14
Also, lymphomas require a comparatively higher number of diagnostic markers than other cancer types.7,15 The World Health Organization (WHO) classification of lymphoid tumors and recommended diagnostic tests continue to expand with diagnostic algorithms differing by category, family, entity, and subtype.16
As a partner with an established focus on pathology and a proven track record for excellence, Roche’s comprehensive solutions address the growing need for precise typing and subtyping, driven by evolving guidelines and cutting-edge molecular techniques.
Featured products
Benefits of Roche diagnostic solutions for managing blood cancers
At the forefront of innovation by developing new solutions
Roche is committed to staying ahead of rapidly evolving diagnostic and treatment approaches for hematologic malignancies:
- Proven experience in advancing science in hematology: The founder of Ventana Medical Systems, now part of Roche Diagnostics, Dr. Tom Grogan, is an expert in hematopathology. His work in this area was transformative to this field, as it aided disease discovery and subtype classification and led the way for an integrated classification of hematopoietic neoplasms.17
- Continuously enhancing IHC stain performance: We are continually improving our diagnostic solutions, such as the new CD8 (SP239) Rabbit Monoclonal Primary Antibody and CD68 (SP251v18) Rabbit Monoclonal Antibody, developed with recombinant technology to offer consistent and reproducible results.18,19
- Investment in cutting-edge technologies: The VENTANA Kappa and Lambda Dual ISH assay is an innovative product designed to deliver multiple clinical benefits over the existing methodologies.20
- Invest in research: We also continue to invest in R&D to bring new solutions across various areas to the oncology community.
Solutions designed to work across the patient journey
Roche provides a comprehensive portfolio of solutions for blood cancers (hematologic malignancies) across the patient journey, empowering clinicians to make timely and confident decisions that drive better patient outcomes.
Diagnosis, typing, and subtyping: Roche offers a broad menu of hematopathology assays tailored for a variety of clinical needs. Specifically, the VENTANA Kappa and Lambda Dual ISH assay is designed to deliver multiple clinical benefits over the existing methodologies.20
Identifying potential targeted therapy options: Companion diagnostics are crucial as they identify specific genetic mutations and provide comprehensive genomic profiles, enabling personalized and effective treatment plans. For example:
- The cobas® EZH2 CDx assay is a real-time, allele-specific polymerase chain reaction (PCR) test that has been approved for the identification of follicular lymphoma patients with an EZH2 mutation for treatment with TAZVERIK™ (tazemetostat), in accordance with the approved therapeutic product labeling.21,22
Our solutions are designed to elevate laboratory efficiency, safety, and standardization through market-leading, fully automated instruments and workflow solutions:
- Proven track record: 100 million IHC and ISH slides stained annually on BenchMark systems worldwide, backed by over 40 years of experience and nine generations of innovation.
Innovation through collaboration
By taking a collaborative approach with our partners and customers, Roche’s expertise provides enduring support for your practice. Our business model focuses on:
- Engaging with professional societies and experts to advance independent lymphoma research and sponsor educational programs27
- Collaborating with researchers to develop new technologies that can improve lymphoma diagnosis20
- Demonstrating ongoing innovation by investing in cutting-edge diagnostics with continuous growth in R&D investments28
Explore more
References
- F. Hoffmann-La Roche Ltd. Roche named among top three most sustainable healthcare companies in the Dow Jones Sustainability Indices. [Internet; cited 2025 Jan 13]. Available from https://www.roche.com/investors/updates/inv-update-2023-12-15.
- F. Hoffmann-La Roche Ltd. Data on file.
- Acharya P, et al. The ABCs of finding a good antibody: How to find a good antibody, validate it, and publish meaningful data. F1000Res. 2017;6:851.
- Zhang N, et al. Global burden of hematologic malignancies and evolution patterns over the past 30 years. Blood Cancer J. 2023;13(1):82.
- Chen Y, et al. Estimates of the global burden of non-Hodgkin lymphoma attributable to HIV: a population attributable modeling study. EClinicalMedicine. 2023;67:102370.
- Ferlay J, et al. Global Cancer Observatory: Cancer Today [Internet; cited 2024 Dec 20]. Available from: https://gco.iarc.who.int/media/globocan/factsheets/cancers/34-non-hodgkin-lymphoma-fact-sheet.pdf.
- PDQ Adult Treatment Editorial Board. Non-Hodgkin Lymphoma Treatment (PDQ®): Health Professional Version [Internet; cited 2024 Dec 20]. Available from: https://www.ncbi.nlm.nih.gov/books/NBK66057/.
- Wagner E. DLBCL Relapse Chances and Treatment Options. MyLymphomaTeam [Internet; cited 2024 Dec 20]. Available from: https://www.mylymphomateam.com/resources/dlbcl-relapse-chances-and-treatment-options.
- Zakeri M, et al. Incremental health care expenditures for non-Hodgkin lymphoma in comparison with other cancers: Analysis of national survey data. J Manag Care Spec Pharm. 2023;29(5):480-489.
- Run R, et al. Diagnostic and predictive biomarkers for lymphoma. Modern Pathology. 2016;29:1118–1142.
- National Comprehensive Cancer Network. NCCN Guidelines Treatment by Cancer Type [Internet; cited 2024 Dec 20]. Available from: https://www.nccn.org/guidelines/category_1.
- Royal College of Pathologists. Standards for specialist laboratory integration and Dataset for the histopathological reporting of lymphomas [Internet; cited 2024 Dec 20]. Available from: https://www.rcpath.org/static/de0b5b4a-7f77-4fe2-ab56fd618ee69098/G142-LymphomaDataset-Oct15.pdf.
- Campo E, et al. The International Consensus Classification of Mature Lymphoid Neoplasms: a report from the Clinical Advisory Committee. Blood. 2022;140(11): 1229-1253.
- Lee J, et al. Diffuse Large B-Cell lymphoma Misdiagnosed as a Hematoma: Case Report. Medicina (Kaunas.) 2023;59(10):1775.
- National Cancer Institute at the National Institutes of Health. Tumor Marker Tests in Common Use [Internet; cited 2024 Dec 20]. Available from: https://www.cancer.gov/about-cancer/diagnosis-staging/diagnosis/tumor-markers-list.
- Alaggio R, et al. The 5th Edition of the World Health Organization Classification of Haematolymphoid Tumours: Lymphoid Neoplasms. Leukemia. 2022; 36:1720-1748.
- Natkunam Y, Warnke RA. On the Shoulders of a Giant: Contributions of Thomas Grogan, MD to Hematopathology. Hemato. 2021; 2(1):103-115.
- F. Hoffmann-La Roche Ltd. Anti-CD8 (SP239) Rabbit Monoclonal Primary Antibody Method sheet. (vA). 2023.
- F. Hoffmann-La Roche Ltd. CD68 (SP251v18) Rabbit Monoclonal Antibody Method sheet. (vA). 2024.
- Rimsza LM, et al. Kappa and lambda light chain mRNA in situ hybridization compared to flow cytometry and immunohistochemistry in B cell lymphomas. Diagn Pathol. 2014;9:144.
- Shyu JY, et al. Performance of the cobas EZH2 mutation test on clinical samples from non-Hodgkin lymphoma patients. PLoS One. 2023;18(12):e0292251.
- F. Hoffmann-La Roche Ltd. cobas® EZH2 Mutation Test [Internet; cited 2024 Dec 20]. Available from: https://www.accessdata.fda.gov/cdrh_docs/pdf20/P200014C.pdf.
- Foundation Medicine. FoundationOne Heme assay [Internet; cited 2024 Dec 20]. Available from: https://www.foundationmedicine.qarad.eifu.online/foundationmedicine/en/foundationmedicine?keycode=454269579.
- Yaung SJ, Pek A. From Information Overload to Actionable Insights: Digital Solutions for Interpreting Cancer Variants from Genomic Testing. Journal of Molecular Pathology. 2021; 2(4):312-318.
- F. Hoffmann-La Roche Ltd. Data on file.
- European Association for Haematopathology. List of Sponsors 2024 [Internet; cited 2024 Dec 20]. Available from: https://www.ea4hp-sh2024.com/list-sponsors-2024/.
- F. Hoffmann-La Roche Ltd. Annual Report 2023 [Internet; cited 2024 Dec 20]. Available from: https://www.roche.com/investors/annualreport23.